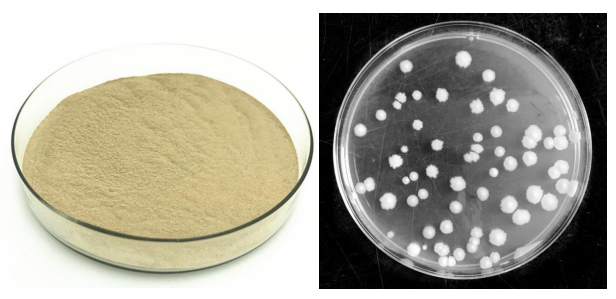

1.Product Introduction:
1.1 Bacillus amyloliquefaciens is a genus of bacillus. It is closely related to Bacillus subtilis. Under extreme conditions,Bacillus amyloliquefaciens can induce endospores with strong stress resistance.Odor: slight fermented flavor.
Bacillus Amyloliquefaciens
10Billion/g
20Billion/g
50Billion/g
100 billion/g
200Billion /g
Before use, soak 1 kg of the product with appropriate brown sugar and pond water for 2-3 hours, and then sprinkle the whole pond. Pay attention to open the aerator is conducive to the reproduction of live bacteria. High temperature season: recom- mended to use with lactic acid bacteria.


Ms Wendy Lee
Mobile&Wechat&Whatsapp : 0086 13562692198
Email :yuedongbiotech@aliyun.com
Ms Jeff Wang
Mobile&Wechat&Whatsapp : 0086 13563622867
Email :wfyuedong@aliyun.com
Ms Sundy Lee
Mobile&Wechat&Whatsapp : 0086 15965090376
Email :yuedongsundy@aliyun.com

